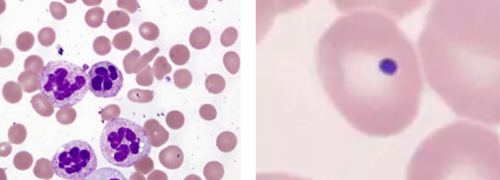

Fallvorstellung: Blutbildveränderungen beim Vitamin B12-Mangel
Eine 68-jährige Patientin stellte sich bei zunehmender Abgeschlagenheit und gehäuften Infekten in der Arztpraxis vor.
DR. MED. ADRIANNA JAGIELLO
Labordiagnostisch wurde zunächst ein großes Blutbild bestimmt (s. Abb. 1). Dabei zeigte sich eine Bizytopenie: eine Leukopenie mit einer schweren Neutropenie von 0,23 G/l (RW: 1,7–7,2) und eine makrozytäre, hyperchrome Anämie von 9,4 g/dl (RW: 12,0–15,4).

Abbildung 1. Großes Blutbild
Differenzialdiagnostisch kamen hier vor allem eine akute Leukämie, eine toxische Ursache und ein Substratmangel in Frage. Eine akute Leukämie konnte mittels eines manuellen Differenzialblutbildes ausgeschlossen werden, da mikroskopisch keine Blasten zu sehen waren. Anamnestisch gab es des Weiteren keinen Hinweis auf eine toxische Genese der Blutbildveränderungen. Die Patientin berichtete bei weiteren Nachfragen, dass sie sich seit Jahren vegetarisch ernähren würde. Daraufhin erfolgte eine Vitamin B12-Bestimmung, die einen deutlich erniedrigten Wert ergab (s. Abb. 2). Nach Substitution von Vitamin B12 normalisierten sich die Blutbildbefunde im Verlauf.

Abbildung 2. Vitamin B12-Bestimmung
Vitamin B12 (Cobalamin) ist ein essentielles Vitamin für die DNA-Synthese, das vorallem über tierische Nahrungsmittel aufgenommen wird. Bei einem Mangel kommt es zu einer Störung der Zellbildung, vornehmlich der Kerne. Am stärksten ist die Erythropoese betroffen, aber auch die anderen Zelllinien können betroffen sein, so dass eine Panzytopenie mit einer stark erhöhten LDH (häufig > 1000 U/l) typisch ist.
Die Anämie ist hyperchrom und makrozytär, außerdem sind die Retikulozyten erniedrigt, da es zu keiner Ausreifung der Erythrozytenvorstufen kommt. Im Ausstrich kann man neben der Panzytopenie folgende Veränderungen feststellen: Anisozytose, Poikilozytose, Polychromasie, basophile Tüpfelung der Erythrozyten, Jolly-Körperchen und hypersegmetierte Granulozyten (s. Abb. 3).
Abbildung 3. Manuelles Differenzialblutbild: Hypersegmetierte Granulozyten (links), Jolly-Körperchen (rechts)
Bei einem Vitamin B12-Mangel ist nicht nur die Bildung der Blutzellen gestört, sondern auch die Bildung der Nervenzellen, so dass neurologische Ausfälle auftreten können. Die Schädigung dieser ist im Gegensatz zur Störung der Erythropoese nicht reversibel und es resultieren bleibende Schäden. Anzumerken ist, dass nur ein kleiner Teil der Patienten mit Vitamin B12-Mangel auch Blutbildveränderungen (megaloblastäre Anämie) hat. Besonders im Alter gehen die neurologisch-psychiatrischen Symptome (Gangataxie, Parästhesien, Abnahme des Vibrations- und Lagesinns, Kraftlosigkeit, kognitive Störungen, Antriebsminderung, Depression, Demenz) den hämatologischen Veränderungen häufig um Monate bis Jahre voraus, sodass schon bei einem klinischen V. a. einen Vitamin B12-Mangel auch ohne Blutbildveränderungen eine Vitamin B12-Bestimmmung erfolgen sollte.
Wichtigste Ursachen des Mangels sind:
- Mangelnde Zufuhr (bei 40 % der Vegetarier, Alkoholkonsum, Neugeborene/gestillte Kleinkinder von vegetarischen Müttern)
- Malabsorption bei intestinalen Erkrankungen, z. B.
- Intrinisic-Faktor-Defizit (Perniziöse Anämie, Z. n. Gastrektomie)
- Achlorhydrie (häufig im Alter), atrophische Gastritis (H. pylori), H2- oder Protonenpumpenblocker, bakterielle Überwucherung, Pankreasinsuffizienz, M. Crohn
Unsere Laborinformation zur Vitamin B12-Bestimmung finden Sie hier unter dem Punkt Hämatologie.